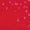
#3_Red, variant on Women 2025 Valentines Shirts Spring 3/4 Sleeve Tunic Tops Cute Heart Print Gift Blouse Trendy Aesthetic 3D Print Tunic Top(Red,XL)

Best of SweatersBlack Lives Matter ClothingFleece ClothingJewelry & AccessoriesLoungewearOnly at Walmart FashionRain GearShop All Garfield ClothingSocksThe Denim ShopThermal Underwear for the FamilyTotal apparel wear to workWinter Puffer JacketsWomens Petite PlusAll Graphic ClothingAnimal PajamasBaby Boys Coats & JacketsBaby ClothesBaby Girls Coats & JacketsBackpacksBags & AccessoriesBarbie ApparelBatman ClothingBeach AccessoriesBig and Tall Workout ClothingBig & Tall Pajamas and RobesBig and TallBig and Tall Coats and JacketsBig and Tall Hoodies and SweatshirtsBig and Tall JeansBig and Tall PantsBig and Tall ScrubsBig and Tall ShirtsBig and Tall ShortsBig and Tall SuitsBig and Tall SweatersBig and Tall SwimwearBig and Tall UnderwearBig and Tall Work ClothingBirthstone JewelryBlack Panther ClothingBlack ScrubsBlue Navy ScrubsBluey ClothingBoys Back to School FashionBoys ClothingBoys Coats and JacketsBoys School UniformsBraceletsCasual ShoesCharacter ShoesChrissy's Most LovedChristmas AccessoriesChristmas Onesie PajamasChristmas PajamasChristmas SlippersChristmas SocksClogsCoats and JacketsCollectible Coins & BullionCouples Christmas PajamasDisney PajamasEarringsFashion JewelryFine JewelryFortnite ClothingGemstone JewelryGirls Back to School FashionGirls ClothingGirls Coats & JacketsGirls School Uniform StoreGold JewelryGraphic ShortsGraphic TeesGreen ScrubsGrey ScrubsGrinch PajamasGround Up ShoesGym BagsHair AccessoriesHalloween Pajama PantsHalloween PajamasHanukkah Clothing & AccessoriesHarry Potter ClothingHats, Gloves & ScarvesHeated ApparelHeated JacketsHello Kitty PajamasHocus Pocus Clothing & AccessoriesHoliday ClothingHoliday Party OutfitsJewelryJewelry & WatchesJuniors ActivewearJuniors Coats & JacketsJuniors Dresses & RompersJuniors Graphic ClothingJuniors Graphic TeesJuniors JeansJuniors Pants & LeggingsJuniors PlusJuniors Plus ActivewearJuniors Plus Coats & JacketsJuniors Plus Dresses & RompersJuniors Plus JeansJuniors Plus Pants & LeggingsJuniors Plus ShortsJuniors Plus SweatersJuniors Plus Sweatshirts & HoodiesJuniors Plus SwimsuitsJuniors Plus Tops & T-ShirtsJuniors ShortsJuniors SweatersJuniors Sweatshirts & HoodiesJuniors SwimsuitsJuniors Tops & T-ShirtsJurassic World ClothingKid's & Baby Cold Weather ClothingKids ActivewearKids Bags and AccessoriesKids Birthday OutfitsKids ClothingKids Coats & JacketsKids Fleece ClothingKids Graphic TeesKids JeansKids New ArrivalsKids PajamasKids Rain CoatsKids Shirts & TopsKids SweatersKids SwimsuitsKids' Winter ClothingMatching Christmas PajamasMatching Halloween PajamasMaternity ActivewearMaternity Belly Bands & AccessoriesMaternity ClothesMaternity Coats & JacketsMaternity DressesMaternity JeansMaternity Pajamas & LoungewearMaternity Pants & LeggingsMaternity Plus ActivewearMaternity Plus CaprisMaternity Plus Coats & JacketsMaternity Plus DressesMaternity Plus JeansMaternity Plus LeggingsMaternity Plus PantsMaternity Plus ShortsMaternity Plus SweatersMaternity Plus Sweatshirts & HoodiesMaternity Plus SwimwearMaternity Plus Tops & T-ShirtsMaternity ShortsMaternity SweatersMaternity SweatshirtsMaternity SwimsuitsMaternity Tops & T-ShirtsMen's Bags & AccessoriesMen's Winter ClothesMens Best Clothing BrandsMens Business CasualMens Coats and JacketsMens Fall OutfitsMens Graphic SweatpantsMens Heated JacketsMens JeansMens Jewelry & WatchesMens MultipacksMens Pajamas and RobesMens PantsMens ScrubsMens ShirtsMens ShoesMens ShortsMens Snow PantsMens SocksMens Stocking StuffersMens SuitsMens Summer OutfitsMens SweatersMens SwimwearMens UndershirtsMens UnderwearMens Workout ClothingMens WorkwearMickey Mouse ClothingMommy and Me ClothingNecklacesNursing Bras & Maternity PantiesPeanuts ClothingPlaid Pajama PantsPlaid PajamasPlus Size ActivewearPlus Size CoatsPlus Size DressesPlus Size JeansPlus Size Jumpsuits & RompersPlus Size PantsPlus Size ScrubsPlus Size ShortsPlus Size SweatersPlus Size TopsPokemon ApparelPre-Owned Women's ClothingPremium Bags & AccessoriesPremium Kids ClothingPremium Mens ClothingPremium Womens ClothingRain AccessoriesRingsRunning Apparel and ShoesSchool UniformsScrub JacketsScrub PantsScrub SetsScrub TopsScrubsShoesSnoopy PajamasSpider-Man ClothingSpongeBob ApparelStar Wars ClothingStranger Things ApparelSunglassesThe Wedding Ring ShopToddler Back to School FashionToddler Boys Coats & JacketsToddler ClothingToddler Girls Coats & JacketsTop Gun ClothingTop Rated Womens ScrubsToy Story ClothingValentine's Day OutfitsValentine's Day Outfits for Baby and ToddlerValentine's Day Outfits for KidsValentine's Day Outfits for WomenValentine's PajamasVirtual try-on shop allWalletsWater ShoesWedding Guest BagsWhite ScrubsWinnie the Pooh ClothingWomen's Bags & AccessoriesWomens ActivewearWomens Bras, Panties & LingerieWomens CoatsWomens DressesWomens Graphic TeesWomens Halloween PajamasWomens JeansWomens Jumpsuits & RompersWomens Pajamas & LoungewearWomens PantsWomens Petite ActivewearWomens Petite Coats & JacketsWomens Petite Dresses & RompersWomens Petite JeansWomens Petite Pants & LeggingsWomens Petite ShortsWomens Petite SkirtsWomens Petite SweatersWomens Petite Sweatshirts & HoodiesWomens Petite SwimwearWomens Petites Tops & T-ShirtsWomens PlusWomens Plus Size Pajamas & LoungewearWomens Plus SkirtsWomens Plus SwimsuitsWomens Plus ThermalsWomens Plus Workwear & SuitsWomens ScrubsWomens ShoesWomens ShortsWomens SkirtsWomens Socks, Hosiery & TightsWomens SweatersWomens Sweatshirts & HoodiesWomens SwimsuitsWomens Thermal UnderwearWomens TopsWomens WorkwearWorkout AccessoriesYoung Adult ClothingYoung Men's Clothing
Best of SweatersBlack Lives Matter ClothingFleece ClothingJewelry & AccessoriesLoungewearOnly at Walmart FashionRain GearShop All Garfield ClothingSocksThe Denim ShopThermal Underwear for the FamilyTotal apparel wear to workWinter Puffer JacketsWomens Petite PlusAll Graphic ClothingAnimal PajamasBaby Boys Coats & JacketsBaby ClothesBaby Girls Coats & JacketsBackpacksBags & AccessoriesBarbie ApparelBatman ClothingBeach AccessoriesBig and Tall Workout ClothingBig & Tall Pajamas and RobesBig and TallBig and Tall Coats and JacketsBig and Tall Hoodies and SweatshirtsBig and Tall JeansBig and Tall PantsBig and Tall ScrubsBig and Tall ShirtsBig and Tall ShortsBig and Tall SuitsBig and Tall SweatersBig and Tall SwimwearBig and Tall UnderwearBig and Tall Work ClothingBirthstone JewelryBlack Panther ClothingBlack ScrubsBlue Navy ScrubsBluey ClothingBoys Back to School FashionBoys ClothingBoys Coats and JacketsBoys School UniformsBraceletsCasual ShoesCharacter ShoesChrissy's Most LovedChristmas AccessoriesChristmas Onesie PajamasChristmas PajamasChristmas SlippersChristmas SocksClogsCoats and JacketsCollectible Coins & BullionCouples Christmas PajamasDisney PajamasEarringsFashion JewelryFine JewelryFortnite ClothingGemstone JewelryGirls Back to School FashionGirls ClothingGirls Coats & JacketsGirls School Uniform StoreGold JewelryGraphic ShortsGraphic TeesGreen ScrubsGrey ScrubsGrinch PajamasGround Up ShoesGym BagsHair AccessoriesHalloween Pajama PantsHalloween PajamasHanukkah Clothing & AccessoriesHarry Potter ClothingHats, Gloves & ScarvesHeated ApparelHeated JacketsHello Kitty PajamasHocus Pocus Clothing & AccessoriesHoliday ClothingHoliday Party OutfitsJewelryJewelry & WatchesJuniors ActivewearJuniors Coats & JacketsJuniors Dresses & RompersJuniors Graphic ClothingJuniors Graphic TeesJuniors JeansJuniors Pants & LeggingsJuniors PlusJuniors Plus ActivewearJuniors Plus Coats & JacketsJuniors Plus Dresses & RompersJuniors Plus JeansJuniors Plus Pants & LeggingsJuniors Plus ShortsJuniors Plus SweatersJuniors Plus Sweatshirts & HoodiesJuniors Plus SwimsuitsJuniors Plus Tops & T-ShirtsJuniors ShortsJuniors SweatersJuniors Sweatshirts & HoodiesJuniors SwimsuitsJuniors Tops & T-ShirtsJurassic World ClothingKid's & Baby Cold Weather ClothingKids ActivewearKids Bags and AccessoriesKids Birthday OutfitsKids ClothingKids Coats & JacketsKids Fleece ClothingKids Graphic TeesKids JeansKids New ArrivalsKids PajamasKids Rain CoatsKids Shirts & TopsKids SweatersKids SwimsuitsKids' Winter ClothingMatching Christmas PajamasMatching Halloween PajamasMaternity ActivewearMaternity Belly Bands & AccessoriesMaternity ClothesMaternity Coats & JacketsMaternity DressesMaternity JeansMaternity Pajamas & LoungewearMaternity Pants & LeggingsMaternity Plus ActivewearMaternity Plus CaprisMaternity Plus Coats & JacketsMaternity Plus DressesMaternity Plus JeansMaternity Plus LeggingsMaternity Plus PantsMaternity Plus ShortsMaternity Plus SweatersMaternity Plus Sweatshirts & HoodiesMaternity Plus SwimwearMaternity Plus Tops & T-ShirtsMaternity ShortsMaternity SweatersMaternity SweatshirtsMaternity SwimsuitsMaternity Tops & T-ShirtsMen's Bags & AccessoriesMen's Winter ClothesMens Best Clothing BrandsMens Business CasualMens Coats and JacketsMens Fall OutfitsMens Graphic SweatpantsMens Heated JacketsMens JeansMens Jewelry & WatchesMens MultipacksMens Pajamas and RobesMens PantsMens ScrubsMens ShirtsMens ShoesMens ShortsMens Snow PantsMens SocksMens Stocking StuffersMens SuitsMens Summer OutfitsMens SweatersMens SwimwearMens UndershirtsMens UnderwearMens Workout ClothingMens WorkwearMickey Mouse ClothingMommy and Me ClothingNecklacesNursing Bras & Maternity PantiesPeanuts ClothingPlaid Pajama PantsPlaid PajamasPlus Size ActivewearPlus Size CoatsPlus Size DressesPlus Size JeansPlus Size Jumpsuits & RompersPlus Size PantsPlus Size ScrubsPlus Size ShortsPlus Size SweatersPlus Size TopsPokemon ApparelPre-Owned Women's ClothingPremium Bags & AccessoriesPremium Kids ClothingPremium Mens ClothingPremium Womens ClothingRain AccessoriesRingsRunning Apparel and ShoesSchool UniformsScrub JacketsScrub PantsScrub SetsScrub TopsScrubsShoesSnoopy PajamasSpider-Man ClothingSpongeBob ApparelStar Wars ClothingStranger Things ApparelSunglassesThe Wedding Ring ShopToddler Back to School FashionToddler Boys Coats & JacketsToddler ClothingToddler Girls Coats & JacketsTop Gun ClothingTop Rated Womens ScrubsToy Story ClothingValentine's Day OutfitsValentine's Day Outfits for Baby and ToddlerValentine's Day Outfits for KidsValentine's Day Outfits for WomenValentine's PajamasVirtual try-on shop allWalletsWater ShoesWedding Guest BagsWhite ScrubsWinnie the Pooh ClothingWomen's Bags & AccessoriesWomens ActivewearWomens Bras, Panties & LingerieWomens CoatsWomens DressesWomens Graphic TeesWomens Halloween PajamasWomens JeansWomens Jumpsuits & RompersWomens Pajamas & LoungewearWomens PantsWomens Petite ActivewearWomens Petite Coats & JacketsWomens Petite Dresses & RompersWomens Petite JeansWomens Petite Pants & LeggingsWomens Petite ShortsWomens Petite SkirtsWomens Petite SweatersWomens Petite Sweatshirts & HoodiesWomens Petite SwimwearWomens Petites Tops & T-ShirtsWomens PlusWomens Plus Size Pajamas & LoungewearWomens Plus SkirtsWomens Plus SwimsuitsWomens Plus ThermalsWomens Plus Workwear & SuitsWomens ScrubsWomens ShoesWomens ShortsWomens SkirtsWomens Socks, Hosiery & TightsWomens SweatersWomens Sweatshirts & HoodiesWomens SwimsuitsWomens Thermal UnderwearWomens TopsWomens WorkwearWorkout AccessoriesYoung Adult ClothingYoung Men's Clothing
3d Xl
Uses item details. Price when purchased online